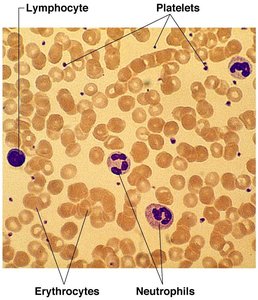
Photomicrograph of a blood smear with labeled cell types

BackChapter 10 – Blood: Composition, Functions, and Clinical Aspects
Study Guide - Smart Notes
Tailored notes based on your materials, expanded with key definitions, examples, and context.
Blood: Composition and Functions
Overview of Blood
Blood is the only fluid tissue in the human body and is classified as a connective tissue. It consists of living cells, known as formed elements, suspended in a non-living matrix called plasma. Blood plays a critical role in transport, regulation, and protection within the body.
Volume: 5–6 liters in a healthy adult male (about 8% of body weight)
pH: Maintained between 7.35–7.45
Color: Scarlet red when oxygen-rich, dull red when oxygen-poor
Components of Blood
Formed Elements: Erythrocytes (RBCs), Leukocytes (WBCs), Platelets
Plasma: 90% water, contains nutrients, electrolytes, respiratory gases, hormones, plasma proteins, and waste products
Plasma Proteins: Albumin (regulates osmotic pressure), clotting proteins, and antibodies.
Formed Elements of Blood
Main Types and Functions
The formed elements of blood include erythrocytes, leukocytes, and platelets, each with distinct functions essential for homeostasis.
Erythrocytes (Red Blood Cells): Transport oxygen and help transport carbon dioxide
Leukocytes (White Blood Cells): Defense and immunity
Platelets: Blood clotting

Blood Smear and Cell Identification
A blood smear under the microscope reveals the various formed elements, including erythrocytes, leukocytes (such as lymphocytes and neutrophils), and platelets. This visualization aids in the identification and study of blood cell morphology.
Characteristics of Formed Elements
Each formed element has unique anatomical and functional characteristics. Leukocytes are further divided into granulocytes and agranulocytes, with specific roles in immune defense. Platelets are essential for hemostasis.
Cell Type | Occurrence in Blood (per mm3) | Cell Anatomy | Function |
|---|---|---|---|
Lymphocytes | 1500–3000 (20–45% of WBCs) | Pale blue cytoplasm, large dark purple-blue nucleus | Part of immune system; B lymphocytes produce antibodies, T lymphocytes involved in graft rejection, fighting tumors and viruses |
Monocytes | 100–700 (4–8% of WBCs) | Abundant gray-blue cytoplasm, dark blue-purple nucleus (kidney-shaped) | Phagocytosis; important in fighting chronic infection |
Platelets | 150,000–500,000 | Irregularly shaped cell fragments, stain deep purple | Needed for normal blood clotting; help control blood loss from broken vessels |

Erythrocytes and Hemoglobin
Structure and Function
Erythrocytes are biconcave, anucleate cells specialized for oxygen transport. They are essentially sacs of hemoglobin, an iron-containing protein that binds oxygen reversibly. Each erythrocyte contains about 250 million hemoglobin molecules, and normal blood contains 12–18 g of hemoglobin per 100 mL.
Homeostatic Imbalances: Anemia and Polycythemia
Anemia is a condition characterized by a decreased oxygen-carrying capacity of the blood. It can result from a reduction in RBC number, inadequate hemoglobin content, or abnormal hemoglobin. Polycythemia is an abnormal increase in RBCs.
Direct Cause | Resulting From | Leading To |
|---|---|---|
Decrease in RBC number | Sudden hemorrhage, lysis of RBCs, lack of vitamin B12, depression/destruction of bone marrow | Hemorrhagic anemia, hemolytic anemia, pernicious anemia, aplastic anemia |
Inadequate hemoglobin content in RBCs | Lack of iron or slow/prolonged bleeding | Iron deficiency anemia |
Abnormal hemoglobin in RBCs | Genetic defect (e.g., sickle cell anemia) | Sickle cell anemia |

Sickle Cell Anemia vs. Normal Hemoglobin
Sickle cell anemia is caused by a genetic mutation resulting in abnormal hemoglobin, which distorts RBC shape under low oxygen conditions. This leads to impaired oxygen delivery and increased risk of vessel blockage.
Normal Hemoglobin: Glutamic acid at position 6 of the beta chain
Sickle Cell Hemoglobin: Valine replaces glutamic acid at position 6

Blood Groups and Transfusions
ABO Blood Groups
Blood groups are determined by the presence or absence of antigens (A and B) on the surface of erythrocytes. Antibodies are produced against antigens not present in the individual's own blood. Compatibility is crucial for safe transfusions to avoid agglutination.
Blood Group | Frequency (% U.S. population) | RBC Antigens | Plasma Antibodies | Blood that can be received |
|---|---|---|---|---|
AB | 4 (White), 4 (Black), 5 (Asian), <1 (Native American) | A, B | None | A, B, AB, O (Universal recipient) |
B | 11, 20, 27, 4 | B | Anti-A | B, O |
A | 40, 27, 26, 16 | A | Anti-B | A, O |
O | 45, 49, 40, 79 | None | Anti-A, Anti-B | O (Universal donor) |

Blood Typing and Agglutination
Blood typing involves mixing blood samples with anti-A and anti-B sera. Agglutination indicates the presence of the corresponding antigen. This process is essential for determining compatibility before transfusions.

Rh Blood Groups and Clinical Significance
The Rh system is based on the presence or absence of the Rh antigen (D antigen). Most individuals are Rh positive. Problems can arise when Rh– individuals are exposed to Rh+ blood, especially during pregnancy, leading to hemolytic disease of the newborn. Preventive treatment with RhoGAM can inhibit antibody formation.
Rh+: Presence of D antigen
Rh–: Absence of D antigen
Clinical Note: Rh incompatibility is a concern in Rh– mothers carrying Rh+ fetuses, especially in subsequent pregnancies.
Summary Table: Key Blood Concepts
Component | Main Function | Clinical Relevance |
|---|---|---|
Erythrocytes | Oxygen transport | Anemia, polycythemia, sickle cell disease |
Leukocytes | Immunity | Leukocytosis, leukopenia, leukemia |
Platelets | Clotting | Thrombocytopenia, bleeding disorders |
Plasma | Transport of solutes | Edema, clotting disorders |